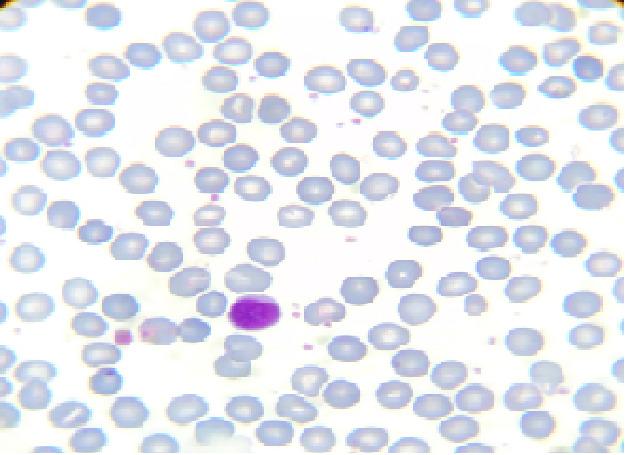

21三体综合征患儿的短暂异常骨髓造血
Transient abnormal myelopoiesis in pediatrics with trisomy 21.
作者信息
Taee Nadereh, Faraji-Goodarzi Mojgan, Safdari Mohammad, Bajelan Amir
机构信息
Department of Pediatrics Faculty of Medicine Lorestan University of Medical Sciences Khorramabad Iran.
Student of Research Committee Lorestan University of Medical Sciences Khorramabad Iran.
出版信息
Clin Case Rep. 2020 Nov 29;9(2):605-608. doi: 10.1002/ccr3.3589. eCollection 2021 Feb.
Transient abnormal myelopoiesis is common among Down syndrome patients. Although no therapeutic measures are required, close monitoring of comorbidities such as gastrointestinal bleeding is required. Long-term follow-up is promising for a healthy future and reduced requirement of unnecessary therapeutic measures including chemotherapy and remission of the pathology.
短暂性异常髓系造血在唐氏综合征患者中很常见。虽然不需要采取治疗措施,但需要密切监测诸如胃肠道出血等合并症。长期随访对于未来保持健康以及减少包括化疗在内的不必要治疗措施的需求和病情缓解很有前景。